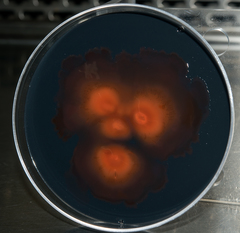
Hymenobacter

Hymenobacter: taxon details and analytics
- Domain
- Kingdom
- Bacteria
- Phylum
- Bacteroidetes
- Class
- Sphingobacteria
- Order
- Sphingobacteriales
- Family
- Flexibacteraceae
- Genus
- Hymenobacter
- Species
- Scientific Name
- Hymenobacter
Summary description from Wikipedia:
Hymenobacter
Hymenobacter is a Gram-negative and non-motile bacterial genus from the family Hymenobacteraceae.
...